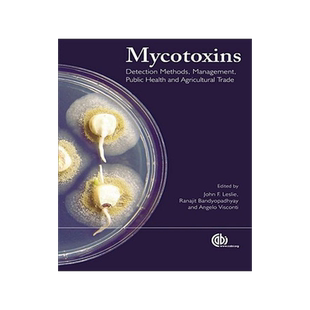
预订 Mycotoxins

![【3-4周达】Mycotoxins in Food and Beverages: Innovations and Advances, Part II [9781032008394]](https://img.alicdn.com/bao/uploaded/i2/2107887916/O1CN01YI8BKc28LaNbeGGRJ_!!4611686018427384108-0-item_pic.jpg_310x310.jpg)
【3-4周达】Mycotoxins in Food and Beverages: Innovations and Advances, Part II [9781032008394]

![【3-4周达】Mycotoxins in Food and Beverages: Innovations and Advances, Part II [9781032008370]](https://img.alicdn.com/bao/uploaded/i3/2107887916/O1CN01cg6vsx28LaNbEfWwL_!!4611686018427384108-0-item_pic.jpg_310x310.jpg)
【3-4周达】Mycotoxins in Food and Beverages: Innovations and Advances, Part II [9781032008370]

![预订 Mycotoxins in Food and Feed: Detection and Management Strategies [9781032113920]](https://img.alicdn.com/bao/uploaded/i3/2107887916/O1CN01Ly3P2u28LaNWg1MsT_!!4611686018427384108-0-item_pic.jpg_310x310.jpg)
预订 Mycotoxins in Food and Feed: Detection and Management Strategies [9781032113920]

![[预订]Application of Novel Methods for Mycotoxins Analysis 9783036535234](https://img.alicdn.com/bao/uploaded/i4/454266620/O1CN01oBwKOS1ym0pnDy7sf_!!2-item_pic.png_310x310.jpg)
[预订]Application of Novel Methods for Mycotoxins Analysis 9783036535234


预订 Mycotoxins: Occurrence, Prevention and Control Approaches: 9786202512732


【预订】Mycotoxins in Plant Disease: Under t...


【预订】Mycotoxins in Animal Products


【预订】Mycotoxins in Animal Products:Milk and Milk Products, and Meat


【预售】Mycotoxins in Feedstuffs


【预订】Mycotoxins in Plant Disease

![[预订]Fusarium: Mycotoxins, Taxonomy and Pathogenicity 9783039434084](https://img.alicdn.com/bao/uploaded/i3/454266620/O1CN01M8tGN31ym0plqeVyx_!!2-item_pic.png_310x310.jpg)
[预订]Fusarium: Mycotoxins, Taxonomy and Pathogenicity 9783039434084

![[预订]The Effects of Mycotoxins on Human and Animal Health-a Special Focus on the Cellular and Molecular M 9783036530284](https://img.alicdn.com/bao/uploaded/i1/454266620/O1CN019ly1H41ym0qqs7LBm_!!2-item_pic.png_310x310.jpg)
[预订]The Effects of Mycotoxins on Human and Animal Health-a Special Focus on the Cellular and Molecular M 9783036530284

![[预订]Mycotoxins in Food and Beverages 9781032008394](https://img.alicdn.com/bao/uploaded/i2/454266620/O1CN01c5TdcS1ym0pB5ms7x_!!2-item_pic.png_310x310.jpg)
[预订]Mycotoxins in Food and Beverages 9781032008394


【预售】Mycotoxins in Feedstuffs

![[预订]Mycotoxins: A Managemental Guide For Animal Husbandry 9789390591541](https://img.alicdn.com/bao/uploaded/i3/454266620/O1CN01RnTB1m1ym0pXndSFU_!!2-item_pic.png_310x310.jpg)
[预订]Mycotoxins: A Managemental Guide For Animal Husbandry 9789390591541

![[预订]Mycotoxins in Food and Beverages 9780367682804](https://img.alicdn.com/bao/uploaded/i2/454266620/O1CN01SEriHn1ym0pknpcxj_!!2-item_pic.png_310x310.jpg)
[预订]Mycotoxins in Food and Beverages 9780367682804


【预订】Mycotoxins in Food and Beverage 9780367422097

![[预订]Mycotoxins in Food and Feed](https://img.alicdn.com/bao/uploaded/i2/454266620/O1CN016Q065u1ym0mXqN6nT_!!2-item_pic.png_310x310.jpg)
[预订]Mycotoxins in Food and Feed


预订 Mycotoxins and phycotoxins: Advances in determination, toxicology and exposure management 霉菌毒素和藻毒素:测定、

![[预订]Promising Detoxification Strategies to Mitigate Mycotoxins in Food and Feed 9783038970279](https://img.alicdn.com/bao/uploaded/i3/454266620/O1CN01KaNQiE1ym0s1S1Iy1_!!2-item_pic.png_310x310.jpg)
[预订]Promising Detoxification Strategies to Mitigate Mycotoxins in Food and Feed 9783038970279


【预订】Mycotoxins in Food and Beverage 9781032008370

![[预订]Fate of Free, Masked and Conjugated/Modified forms of Mycotoxins 9783036501581](https://img.alicdn.com/bao/uploaded/i4/454266620/O1CN016YFN931ym0psMmOMH_!!2-item_pic.png_310x310.jpg)
[预订]Fate of Free, Masked and Conjugated/Modified forms of Mycotoxins 9783036501581


【预售】Encyclopedia of Food Mycotoxins


【预订】Mycotoxins in Food, Feed and Bioweapons


【预订】Mycotoxins in Foodstuffs


【预订】Mycotoxins in Food, Feed and Bioweapons


【预售】Biodeterioration Research: Volume 4: Mycotoxins


【预售】Biodeterioration Research: Mycotoxins, Biotoxins,


【预售】Mycotoxins, Wood Decay, Plant Stress, Biocorro...


预订 Mycotoxins in Food and Feed: Detection and Management Strategies: 9781032150352


【预售】Selected Mycotoxins: Ochratoxins, Trichothecenes


预订 Safety Evaluation of Certain Mycotoxins in Food (WHO Food Additives) (Who Food Additives Series): 9789251046647

预订 Mycotoxins

![[预订]Mycotoxins in Feed and Food Chain: Mycotoxins in Feed and Food Chain 9783039368747](https://img.alicdn.com/bao/uploaded/i3/454266620/O1CN01rd2zoE1ym0prURBD1_!!2-item_pic.png_310x310.jpg)
[预订]Mycotoxins in Feed and Food Chain: Mycotoxins in Feed and Food Chain 9783039368747

![[预订]Mycotoxins Occurence in Feed and Their Influence on Animal Health 9783039438471](https://img.alicdn.com/bao/uploaded/i2/454266620/O1CN01p3W5cL1ym0plRdFfa_!!2-item_pic.png_310x310.jpg)
[预订]Mycotoxins Occurence in Feed and Their Influence on Animal Health 9783039438471


【预售】Mycotoxins

![[预订]Mycotoxins in Aquaculture 9781789180596](https://img.alicdn.com/bao/uploaded/i2/454266620/O1CN01fkZZdL1ym0pNokJnp_!!2-item_pic.png_310x310.jpg)
[预订]Mycotoxins in Aquaculture 9781789180596


【预售】Mycotoxins in Plants and Plant Products: Cocoa, Coffee, Fruits and Fruit Products, Medicinal Plants, Nuts,...


预订 Mycotoxins in Feedstuffs 饲料的真菌毒素 第3版: 9783031666261


预订 Food Safety and Mycotoxins 食物安全及霉菌毒素: 9789392969782

